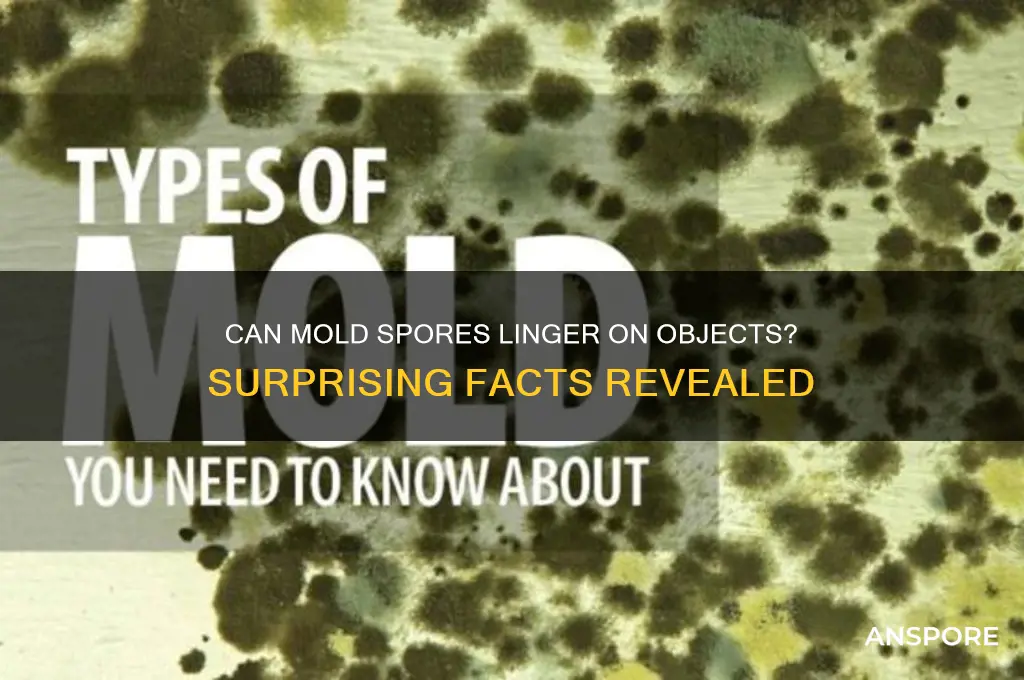
can mold spores stay on objects

Mold spores are microscopic particles that can easily become airborne and settle on various surfaces, making them highly resilient and pervasive. These spores are naturally present in the environment and can attach themselves to objects, clothing, and even pets, allowing them to travel and potentially grow in new locations. The ability of mold spores to remain on objects is a significant concern, as it contributes to their widespread presence and the challenges associated with mold remediation. Understanding the persistence of mold spores on different materials is crucial for effective prevention and control strategies, especially in environments prone to moisture and humidity, where mold growth is more likely to occur.
| Characteristics | Values |
|---|---|
| Can mold spores stay on objects? | Yes, mold spores can adhere to and remain on various surfaces and objects. |
| Duration of survival | Mold spores can survive indefinitely on objects under suitable conditions. |
| Surface types | Spores can stay on porous (e.g., wood, fabric) and non-porous (e.g., glass, metal) materials. |
| Environmental factors | Survival depends on humidity, temperature, and nutrient availability. |
| Dormancy | Spores can remain dormant for long periods until conditions become favorable for growth. |
| Dispersal | Spores can be easily transferred between objects via air, touch, or water. |
| Health risks | Prolonged exposure to mold spores on objects can cause allergies, respiratory issues, and infections. |
| Prevention | Regular cleaning, reducing humidity, and proper ventilation can prevent spore accumulation. |
| Removal | Spores can be removed from objects using disinfectants, HEPA vacuums, or professional remediation. |
Explore related products
$13.48 $14.13
What You'll Learn
- Surface Material Impact: Different materials hold spores differently; porous surfaces retain longer than non-porous ones
- Cleaning Effectiveness: Proper cleaning methods reduce spore presence; incomplete cleaning may leave residues
- Environmental Conditions: Humidity and temperature influence spore survival on objects over time
- Cross-Contamination Risk: Spores can transfer between objects, spreading mold to new areas
- Longevity on Fabrics: Mold spores persist longer on fabrics, especially in damp conditions

Surface Material Impact: Different materials hold spores differently; porous surfaces retain longer than non-porous ones
Mold spores are ubiquitous, but their persistence on objects varies dramatically depending on the surface material. Porous materials like wood, fabric, and drywall act as spore reservoirs, trapping them within microscopic crevices and fibers. Non-porous surfaces such as glass, metal, and plastic, however, offer little hiding space, making spores easier to remove. This distinction is critical for understanding mold risk in homes, workplaces, and healthcare settings, where surface choice can either mitigate or exacerbate spore retention.
Consider a scenario where a leaky pipe causes moisture buildup in a bathroom. If the walls are made of porous drywall, mold spores will embed themselves deeply, requiring aggressive remediation or even material replacement. In contrast, tiles or glass surfaces nearby may accumulate spores but can typically be cleaned with a disinfectant, as the spores remain on the surface. This example underscores the importance of selecting non-porous materials in moisture-prone areas to minimize spore retention and simplify cleaning efforts.
From a practical standpoint, homeowners and facility managers should prioritize material selection based on environmental conditions. In high-humidity zones like kitchens and bathrooms, opt for non-porous materials such as ceramic tiles, stainless steel, or sealed concrete. For areas where porous materials are unavoidable—like carpeted bedrooms or wooden furniture—regular inspections and prompt moisture control are essential. Using HEPA vacuums and mold-inhibiting sprays can also reduce spore accumulation on these surfaces.
The science behind this phenomenon lies in the physical properties of materials. Porous surfaces provide more surface area and microenvironments for spores to adhere to, while non-porous surfaces leave spores exposed and vulnerable to cleaning agents. Studies show that spores on porous materials can remain viable for months, whereas those on non-porous surfaces often lose viability within days if not protected by organic matter. This knowledge empowers individuals to make informed decisions about material use and maintenance.
In conclusion, the impact of surface material on mold spore retention is a critical yet often overlooked factor in mold prevention. By understanding how porous and non-porous materials differ in their ability to hold spores, one can strategically design and maintain spaces to reduce mold risks. Whether renovating a home or managing a commercial property, the choice of materials and proactive cleaning practices can significantly influence indoor air quality and health outcomes.
Can Heat Kill Mold Spores? Effective Temperatures and Methods Explained
You may want to see also

Cleaning Effectiveness: Proper cleaning methods reduce spore presence; incomplete cleaning may leave residues
Mold spores are remarkably resilient, capable of surviving on surfaces for extended periods, even after visible mold has been removed. This persistence underscores the critical importance of thorough cleaning methods to eliminate both mold colonies and their microscopic spores. Proper cleaning not only removes the visible growth but also disrupts the spores’ ability to proliferate, reducing the risk of recurrence. In contrast, incomplete cleaning often leaves behind residues—whether mold fragments, spores, or the organic matter they feed on—creating conditions ripe for regrowth. This cycle highlights why superficial cleaning efforts, while seemingly effective, can be counterproductive in the long term.
Effective mold remediation begins with understanding the tools and techniques required to target spores. For hard, non-porous surfaces, a solution of 1 cup of bleach per gallon of water is recommended by the EPA for killing mold and its spores. However, this method must be followed by thorough rinsing and drying to prevent bleach residue from damaging surfaces or leaving behind chemicals that mold can eventually use as a food source. For porous materials like drywall or fabric, the approach differs; these materials often require disposal since spores can penetrate deeply, making complete removal nearly impossible. The key takeaway is that cleaning methods must be tailored to the surface type and the extent of contamination.
A common pitfall in mold cleaning is the assumption that once the visible mold is gone, the problem is solved. This misconception often leads to incomplete cleaning, where spores remain embedded in cracks, crevices, or porous materials. For instance, wiping down a moldy wall with a damp cloth may remove surface mold but leaves spores intact, especially if the cleaning solution doesn’t penetrate the material. To avoid this, mechanical action—such as scrubbing with a brush or using a HEPA-filtered vacuum—should accompany chemical treatment. Additionally, ensuring proper ventilation during cleaning prevents spore dispersal, which can lead to cross-contamination in other areas of the home.
The role of drying cannot be overstated in mold remediation. Mold spores require moisture to germinate, so even if cleaning removes visible mold, residual dampness can reactivate dormant spores. After cleaning, surfaces should be dried within 24–48 hours using fans, dehumidifiers, or open windows. In humid environments, maintaining indoor humidity below 60% is crucial to inhibit spore growth. This step is often overlooked but is as vital as the cleaning itself, forming a two-pronged approach to spore eradication.
Finally, preventive measures are essential to complement cleaning efforts. Regular inspection of moisture-prone areas—such as bathrooms, basements, and kitchens—can catch mold growth early, when it’s easier to manage. Using mold-resistant products in construction or renovation, such as mold-inhibiting paints or moisture-resistant drywall, can also reduce the likelihood of spore colonization. By combining thorough cleaning with proactive maintenance, homeowners can significantly reduce the presence of mold spores on objects and surfaces, breaking the cycle of regrowth and ensuring a healthier living environment.
Can Spores Survive Cooking at 165°F? The Truth Revealed
You may want to see also

Environmental Conditions: Humidity and temperature influence spore survival on objects over time
Mold spores are remarkably resilient, capable of surviving on objects for extended periods under the right conditions. However, their longevity is not arbitrary; it hinges critically on environmental factors, particularly humidity and temperature. These elements act as the gatekeepers of spore survival, dictating whether they remain dormant, germinate, or perish. Understanding this dynamic is essential for anyone seeking to prevent mold growth in homes, workplaces, or storage areas.
Humidity plays a pivotal role in spore survival, as mold requires moisture to transition from a dormant spore to an active, growing organism. Relative humidity levels above 60% create an ideal environment for spores to absorb water, triggering germination. For instance, spores on damp clothing left in a humid bathroom can begin to grow within 24 to 48 hours. Conversely, maintaining humidity below 50% significantly reduces the risk of spore activation, as the lack of moisture inhibits their ability to hydrate and thrive. Dehumidifiers and proper ventilation are practical tools to control humidity, especially in areas prone to dampness like basements or kitchens.
Temperature, too, is a critical factor in spore survival, though its influence is more nuanced. Mold spores can withstand a wide range of temperatures, from near-freezing to scorching conditions, but their ability to germinate is optimized within a specific window. Most common indoor molds, such as *Aspergillus* and *Penicillium*, thrive between 77°F and 86°F (25°C to 30°C). Below 40°F (4°C), spore germination slows dramatically, while temperatures above 140°F (60°C) can kill spores outright. This explains why refrigeration can delay mold growth on food, while heat treatment is often used to sterilize objects in industrial settings.
The interplay between humidity and temperature creates a delicate balance that determines spore fate. For example, a warm, humid environment accelerates spore germination, as seen in tropical climates where mold proliferates rapidly. Conversely, a cool, dry environment can render spores dormant for years, as evidenced by their survival in arid desert conditions. This highlights the importance of controlling both factors simultaneously for effective mold prevention. In practice, this might involve using air conditioners to lower both temperature and humidity during hot, muggy seasons or employing heaters and dehumidifiers in cold, damp climates.
For those looking to protect objects from mold, the takeaway is clear: monitor and manipulate environmental conditions proactively. Regularly inspect areas prone to moisture accumulation, such as under sinks or behind appliances, and address leaks or condensation promptly. Store susceptible items like books, clothing, and electronics in dry, temperature-controlled spaces. When dealing with mold-contaminated objects, clean them thoroughly and ensure the surrounding environment is unfavorable for spore survival. By understanding and managing humidity and temperature, you can significantly reduce the risk of mold spores taking hold and causing damage.
Exploring Galactic Adventures: Can You Purchase It Without Spore?
You may want to see also
Explore related products

Cross-Contamination Risk: Spores can transfer between objects, spreading mold to new areas
Mold spores are microscopic and lightweight, making them easily transferable from one surface to another. This cross-contamination risk is a significant concern, as it allows mold to spread rapidly to new areas, even those previously unaffected. For instance, a damp towel used to clean a moldy surface can inadvertently carry spores to other rooms, initiating new colonies. Understanding this mechanism is crucial for effective mold management, especially in environments prone to moisture, such as bathrooms, kitchens, and basements.
To mitigate cross-contamination, adopt a zone-cleaning approach. Designate specific cleaning tools (e.g., cloths, brushes) for mold-affected areas and avoid using them elsewhere. For example, a microfiber cloth used to wipe moldy tiles should be discarded or thoroughly disinfected before reuse. Additionally, always clean from the least contaminated areas to the most affected to prevent spreading spores. This methodical approach reduces the likelihood of spores hitchhiking to pristine surfaces.
Consider the role of personal items in spore transfer. Clothing, shoes, and even pets can act as carriers, especially in mold-infested environments. After handling moldy materials or working in affected areas, change clothes and wash them separately to avoid contaminating other laundry. For pets, wipe their paws and fur with a damp cloth before they enter clean zones. These small but deliberate actions can significantly curb the spread of mold spores throughout a space.
Finally, leverage technology to combat cross-contamination. HEPA-filtered vacuums and air purifiers can capture airborne spores, reducing their presence on surfaces. When cleaning mold, use a solution of 1:10 bleach to water or a mold-specific cleaner to kill spores on contact. However, always wear protective gear, including gloves and masks, to avoid inhaling spores. By combining physical barriers, cleaning protocols, and technology, you can effectively minimize the risk of spores transferring between objects and spreading mold to new areas.
Using Milky Spore Safely in Vegetable Gardens: Benefits and Precautions
You may want to see also

Longevity on Fabrics: Mold spores persist longer on fabrics, especially in damp conditions
Mold spores are remarkably resilient, and fabrics provide an ideal environment for their prolonged survival, especially when dampness is present. Unlike hard surfaces where spores may struggle to find purchase, fabrics offer a textured landscape that traps and holds moisture, creating a nurturing ground for mold growth. This is particularly concerning for items like clothing, upholstery, and curtains, which are often exposed to humidity and limited airflow. For instance, a damp towel left crumpled in a corner can become a breeding ground for mold within 24 to 48 hours, with spores persisting for weeks or even months if not addressed.
The longevity of mold spores on fabrics is influenced by several factors, including the type of fabric, humidity levels, and temperature. Natural fibers like cotton and wool are more susceptible to mold due to their ability to retain moisture, while synthetic materials like polyester may resist mold growth but still harbor spores. In environments with relative humidity above 60%, mold spores can remain viable indefinitely, waiting for the right conditions to germinate. This makes damp basements, closets, and bathrooms high-risk areas for fabric contamination.
To mitigate the persistence of mold spores on fabrics, proactive measures are essential. Regularly inspect and clean areas prone to dampness, ensuring fabrics are thoroughly dried after washing or exposure to moisture. For items that cannot be washed, such as upholstery, consider using a HEPA vacuum to remove surface spores. In severe cases, professional cleaning or disposal may be necessary to prevent spore spread. Maintaining indoor humidity below 50% with dehumidifiers can also significantly reduce the risk of mold growth on fabrics.
Comparatively, while mold spores can survive on various objects, their tenacity on fabrics is particularly noteworthy due to the material’s inherent properties. Unlike glass or metal, fabrics provide both a physical anchor and a moisture reservoir, enabling spores to endure harsh conditions. This distinction highlights the need for tailored strategies when dealing with fabric-based mold issues. For example, while wiping down a glass surface with a disinfectant may suffice, treating moldy fabric often requires washing at high temperatures (above 140°F) to effectively kill spores.
In conclusion, the persistence of mold spores on fabrics, especially in damp conditions, underscores the importance of vigilance and targeted interventions. By understanding the unique vulnerabilities of fabrics and implementing preventive measures, individuals can protect their belongings and health from the insidious effects of mold. Whether through routine maintenance, proper storage, or prompt treatment, addressing mold on fabrics requires a proactive and informed approach.
Fungal Spores: Exploring Sexual and Asexual Reproduction Methods
You may want to see also
Frequently asked questions
Yes, mold spores can remain on objects even after cleaning, especially if the cleaning process does not fully remove or kill them. Proper disinfection and drying are essential to prevent regrowth.
Mold spores can survive on surfaces indefinitely under the right conditions, as they are highly resilient. They remain dormant until moisture and nutrients become available for growth.
Yes, mold spores can easily transfer between objects through touch, air movement, or contact with contaminated materials. This makes cross-contamination a concern in mold-affected areas.
Yes, mold spores can be removed from clothing or fabric items by washing them in hot water with detergent and using a mold-killing solution like vinegar or bleach, followed by thorough drying.
Yes, mold spores can stay on electronics and hard surfaces. Cleaning these items with a damp cloth and mild disinfectant can remove spores, but ensure the electronics are powered off and dried properly to avoid damage.

























